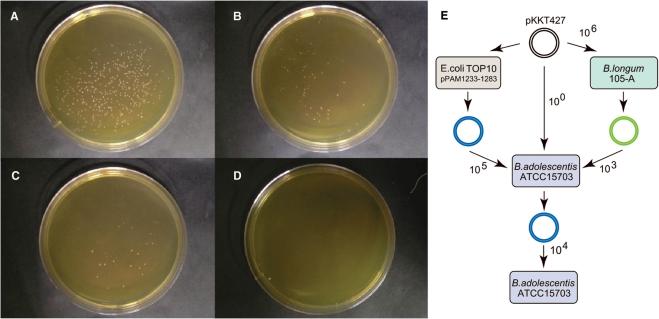

利用质粒人工修饰提高细菌转化效率
Improvement of bacterial transformation efficiency using plasmid artificial modification.
作者信息
Yasui Kazumasa, Kano Yasunobu, Tanaka Kaori, Watanabe Kunitomo, Shimizu-Kadota Mariko, Yoshikawa Hirofumi, Suzuki Tohru
机构信息
The United Graduate School of Agricultural Science, Gifu University, Gifu, Japan.
出版信息
Nucleic Acids Res. 2009 Jan;37(1):e3. doi: 10.1093/nar/gkn884. Epub 2008 Nov 12.
We have developed a method to improve the transformation efficiency in genome-sequenced bacteria, using 'Plasmid Artificial Modification' (PAM), using the host's own restriction system. In this method, a shuttle vector was pre-methylated in Escherichia coli cells, which carry all the putative genes encoding the DNA modification enzymes of the target microorganism, before electroporation was performed. In the case of Bifidobacterium adolescentis ATCC15703 and pKKT427 (3.9 kb E. coli-Bifidobacterium shuttle vector), introducing two Type II DNA methyltransferase genes lead to an enhancement in the transformation efficiency by five orders of magnitude. This concept was also applicable to a Type I restriction system. In the case of Lactococcus lactis IO-1, by using PAM with a putative Type I methyltransferase system, hsdMS1, the transformation efficiency was improved by a factor of seven over that without PAM.
我们开发了一种利用“质粒人工修饰”(PAM)并借助宿主自身限制系统来提高基因组测序细菌转化效率的方法。在该方法中,在进行电穿孔之前,穿梭载体在携带目标微生物所有假定的DNA修饰酶编码基因的大肠杆菌细胞中进行预甲基化。以青春双歧杆菌ATCC15703和pKKT427(3.9 kb大肠杆菌 - 双歧杆菌穿梭载体)为例,引入两个II型DNA甲基转移酶基因可使转化效率提高五个数量级。这一概念也适用于I型限制系统。以乳酸乳球菌IO - 1为例,通过使用带有假定的I型甲基转移酶系统hsdMS1的PAM,转化效率比不使用PAM时提高了七倍。